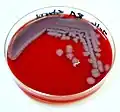
Чистая культура сибирязвенных палочек на плотной элективной питательной среде (кровяной агар) на чашке Петри

Питательная среда


Питательная среда — однокомпонентный или многокомпонентный субстрат, применяемый для культивирования микроорганизмов или культур клеток высших организмов.
Требования, предъявляемые к питательным средам
- быть питательными, то есть содержать в легко усваиваемом виде все вещества, необходимые для удовлетворения пищевых и энергетических потребностей. При культивировании ряда микроорганизмов в среды вносят факторы роста — витамины, некоторые аминокислоты, которые клетка не может синтезировать.
- иметь оптимальную концентрацию водородных ионов — pH, так как только при оптимальной реакции среды, влияющей на проницаемость оболочки, микроорганизмы могут усваивать питательные вещества.
- Для большинства патогенных бактерий оптимальна слабощелочная среда (pH 7,2—7,4). Исключение составляют холерный вибрион — его оптимум находится в щелочной зоне (pH 8,5—9,0) и возбудитель туберкулёза, нуждающийся в слабокислой реакции (pH 6,2—6,8).
- Чтобы во время роста микроорганизмов кислые или щелочные продукты их жизнедеятельности не изменили pH, среды должны обладать буферностью, то есть содержать вещества, нейтрализующие продукты обмена.
- быть изотоничными для микробной клетки; то есть осмотическое давление в среде должно быть таким же, как внутри клетки. Для большинства микроорганизмов оптимальная среда, соответствующая 0,5 % раствору натрия хлорида.
- быть стерильными, так как посторонние микробы препятствуют росту изучаемого микроба, определению его свойств и изменяют свойства среды.
- плотные среды́ должны быть влажными и иметь оптимальную для микроорганизмов консистенцию.
- обладать определённым окислительно-восстановительным потенциалом, то есть соотношением веществ, отдающих и принимающих электроны, выражаемым индексом RH2. Например, анаэробы размножаются при RH2 не выше 5, а аэробы — при RH2 не ниже 10.
- быть по возможности унифицированным, то есть содержать постоянное количество отдельных ингредиентов.
Желательно, чтобы среды были прозрачными — удобнее следить за ростом культур, легче заметить загрязнение среды посторонними микроорганизмами.
Классификация


- По исходным компонентам:
- натуральные среды — готовят из продуктов животного и растительного происхождения (мясо, асцит, костная мука, кормовые дрожжи, сгустки крови и др.)
- синтетические среды — готовят из определённых химически чистых органических и неорганических соединений, взятых в точно указанных концентрациях и растворённых в дважды дистиллированной воде.
- По степени готовности:
- готовые питательные среды (в чашках Петри, во флаконах)
- сухие смеси
- По консистенции (степени плотности):
- жидкие (бульоны)
- полужидкие
- плотные
Плотные и полужидкие среды отличаются от жидких наличием желирующего агента (агар-агар, реже желатин). Кроме того, в качестве плотных сред применяют коагулировавшие яичные или сывороточные белки, картофель, среды с силикагелем. Некоторые микроорганизмы используют желатин как питательное вещество — при их росте среда разжижается.
- По составу:
- простые: мясопептонный бульон (МПБ), мясопептонный агар (МПА), питательный желатин,
- сложные — многокомпонентные среды, которые могут содержать аминокислоты, витамины, микроэлементы и другие вещества.
- По назначению:
- основные — служат для культивирования большинства микроорганизмов, например МПБ, МПА, бульон, шоколадный агар, пептонная вода.
- специальные — служат для выделения и выращивания микроорганизмов, не растущих на простых средах.
- элективные (избирательные) — служат для выделения определённого вида микробов, росту которых они благоприятствуют, задерживая или подавляя рост сопутствующих микроорганизмов. Среды становятся элективными при добавлении к ним определённых антибиотиков, солей, изменения pH. Жидкие элективные среды называют средами накопления.
- дифференциально-диагностические — позволяют отличить один вид микробов от другого по ферментативной активности.
- транспортные — предназначены для первичного посева и транспортировки исследуемого материала.
Приготовление сред
Посуда для приготовления сред
Посуда для приготовления сред не должна содержать посторонних веществ, например щелочей, выделяемых некоторыми сортами стекла, или окислов железа, которые могут попасть в среду при варке её в ржавых кастрюлях. Лучше пользоваться стеклянной, эмалированной или алюминиевой посудой. Перед употреблением посуду необходимо тщательно вымыть, прополоскать и высушить. Новую стеклянную посуду предварительно кипятят 30 минут в 1-2 % растворе хлороводородной кислоты, после чего в течение часа прополаскивают в проточной воде.
Сырьё
Исходным сырьём для приготовления большинства сред служат продукты животного и растительного происхождения, а также готовые полуфабрикаты.
Этапы приготовления
- варка: среды варят на открытом огне, водяной бане, автоклаве, варочных котла или микроволновой печи.
- установление pH: ориентировочно производят с помощью индикаторной бумаги, для точного определения пользуются потенциометром или компаратором. При стерилизации pH снижается на 0,2, поэтому сначала готовят более щелочной раствор.
- осветление производят, если при варке среды мутнеют или темнеют. Для этого используют белок куриного яйца или сыворотку крови.
- фильтрация жидких и расплавленных желатиновых сред производят через влажный бумажный или матерчатый фильтры. Фильтрация агаровых сред затруднена — они быстро застывают. Обычно их фильтруют через ватно-марлевый фильтр.
- разливают среды не более чем на ¾ ёмкости, так как при стерилизации могут намокнуть пробки и среды утратят стерильность.
- стерилизация: режим стерилизации зависит от состава среды и указан в её рецепте.
- контроль
- для контроля стерильности среды ставят на 2 суток в термостат, после чего их просматривают.
- химический контроль окончательно устанавливает pH, содержание общего и амминого азота, пептона, хлоридов.
- для биологического контроля несколько образцов среды засевают специально подобранными культурами, и по их росту судят о питательных свойствах среды.
Виды питательных сред
- Среда типа АГВ (ТУ 9229-083-00419785-97).
- Агаризованная дрожже-молочно-солевая среда (АДМС)
- Среда Байрд-Паркера (агаризованная)
- Среда Блаурокка (агаризованная)
- Среда Бушнелла-Хааса (агаризованная)
- Среда Вильсона-Блера (агаризованная)
- Среда Гамборга (агаризованная)
- Среда Гаузе-1 (агаризованная)
- Среда Кери-Блейра (агаризованная) или среда среда Кери-Блэр (Кэри-Блэир).
- Среда Китт Тароцци (агаризованная)
- Среда Левенштейна-Йенсена.
- Среда Левина-ГРМ
- Среда Леониана (агаризованная, используется в микологии)
- Среда Мак-Конки (агаризованная)
- Среда Мурасиге-Скуга (агаризованная)
- Среда Мюллера-Хинтон (плотная)
- Среда МРС-2 (агаризованная)
- Среда типа MRS (агаризованная) (ГОСТ 51331-99) — латинская аббревиатура предыдущей среды
- Среда типа Neogen
- Среда Рогоза (агаризованная)
- Среда Сабуро (агаризованная, декстрозная, используется в микологии, SDA)
- Среда Смирнова А. М.
- Среда Сотона (агаризованная)
- Среда СР-15 (агаризованная)
- Среда Стрита (агаризованная)
- Среда Стюарта (транспортная)
- Среда триптон-соевый агар (TSA)
- Среда Хейфлика (агаризованная) или Hayflick Liquid Medium
- Среда Чапека (агаризованная)
- Среда Шенка-Хильдебрандта
- Среда Эймса (транспортная) или Amies Liquid Medium
- Среда Эндо (агаризованная)
- Среда Эшби (агаризованная)[1][2]
- Среда LB
Изображения
 Пробирки с жидкими питательными средами (слева 6) для идентификации микроорганизмов по их свойству изменять среды
Пробирки с жидкими питательными средами (слева 6) для идентификации микроорганизмов по их свойству изменять среды- Пробирки с плотной скошенной питательной средой (трёхсахарный железистый агар) засеянными разными микроорганизмами
 Колония грибка микроспории на скошенной плотной питательной среде накопления
Колония грибка микроспории на скошенной плотной питательной среде накопления Чистая культура кишечных палочек на плотной элективной питательной среде (среда Эндо) на чашке Петри
Чистая культура кишечных палочек на плотной элективной питательной среде (среда Эндо) на чашке Петри Чистая культура сибирязвенных палочек на плотной элективной питательной среде (кровяной агар) на чашке Петри
Чистая культура сибирязвенных палочек на плотной элективной питательной среде (кровяной агар) на чашке Петри Чашки Петри с плотными питательными средами
Чашки Петри с плотными питательными средами
См. также
Примечания
Литература
- Замчук Л. А. Питательные среды Архивная копия от 18 января 2021 на Wayback Machine // Большая медицинская энциклопедия, 3-е изд. — М.: Советская энциклопедия. — Т. 19.
- Калина Г. П. Синтетические питательные среды Архивная копия от 11 августа 2017 на Wayback Machine // Большая медицинская энциклопедия, 3-е изд. — М.: Советская энциклопедия. — Т. 23.
- Биргер М. О. Дифференциально-диагностические среды Архивная копия от 29 августа 2017 на Wayback Machine // Большая медицинская энциклопедия, 3-е изд. — М.: Советская энциклопедия. — Т. 7.
- Белокрысенко С. С. Бактериальная культура Архивная копия от 9 декабря 2020 на Wayback Machine // Большая медицинская энциклопедия, 3-е изд. — М.: Советская энциклопедия. — Т. 2.
- Белокрысенко С. С. Гемокультура Архивная копия от 12 июля 2017 на Wayback Machine // Большая медицинская энциклопедия, 3-е изд. — М.: Советская энциклопедия. — Т. 5.
- Белокрысенко С. С. Биологическая проба в микробиологии Архивная копия от 11 июля 2017 на Wayback Machine // Большая медицинская энциклопедия, 3-е изд. — М.: Советская энциклопедия. — Т. 3.
- Игнатова Т. H., Поспелова Т. В., Губин В. А., Добрынин Я. В., Чертков И. Л. Культуры клеток и тканей (питательные среды для культур клеток и тканей) Архивная копия от 26 октября 2020 на Wayback Machine // Большая медицинская энциклопедия, 3-е изд. — М.: Советская энциклопедия. — Т. 12.
- [bse.sci-lib.com/article110808.html Титр бактерий] // Большая советская энциклопедия : [в 30 т.] / гл. ред. А. М. Прохоров. — 3-е изд. — М. : Советская энциклопедия, 1969—1978.